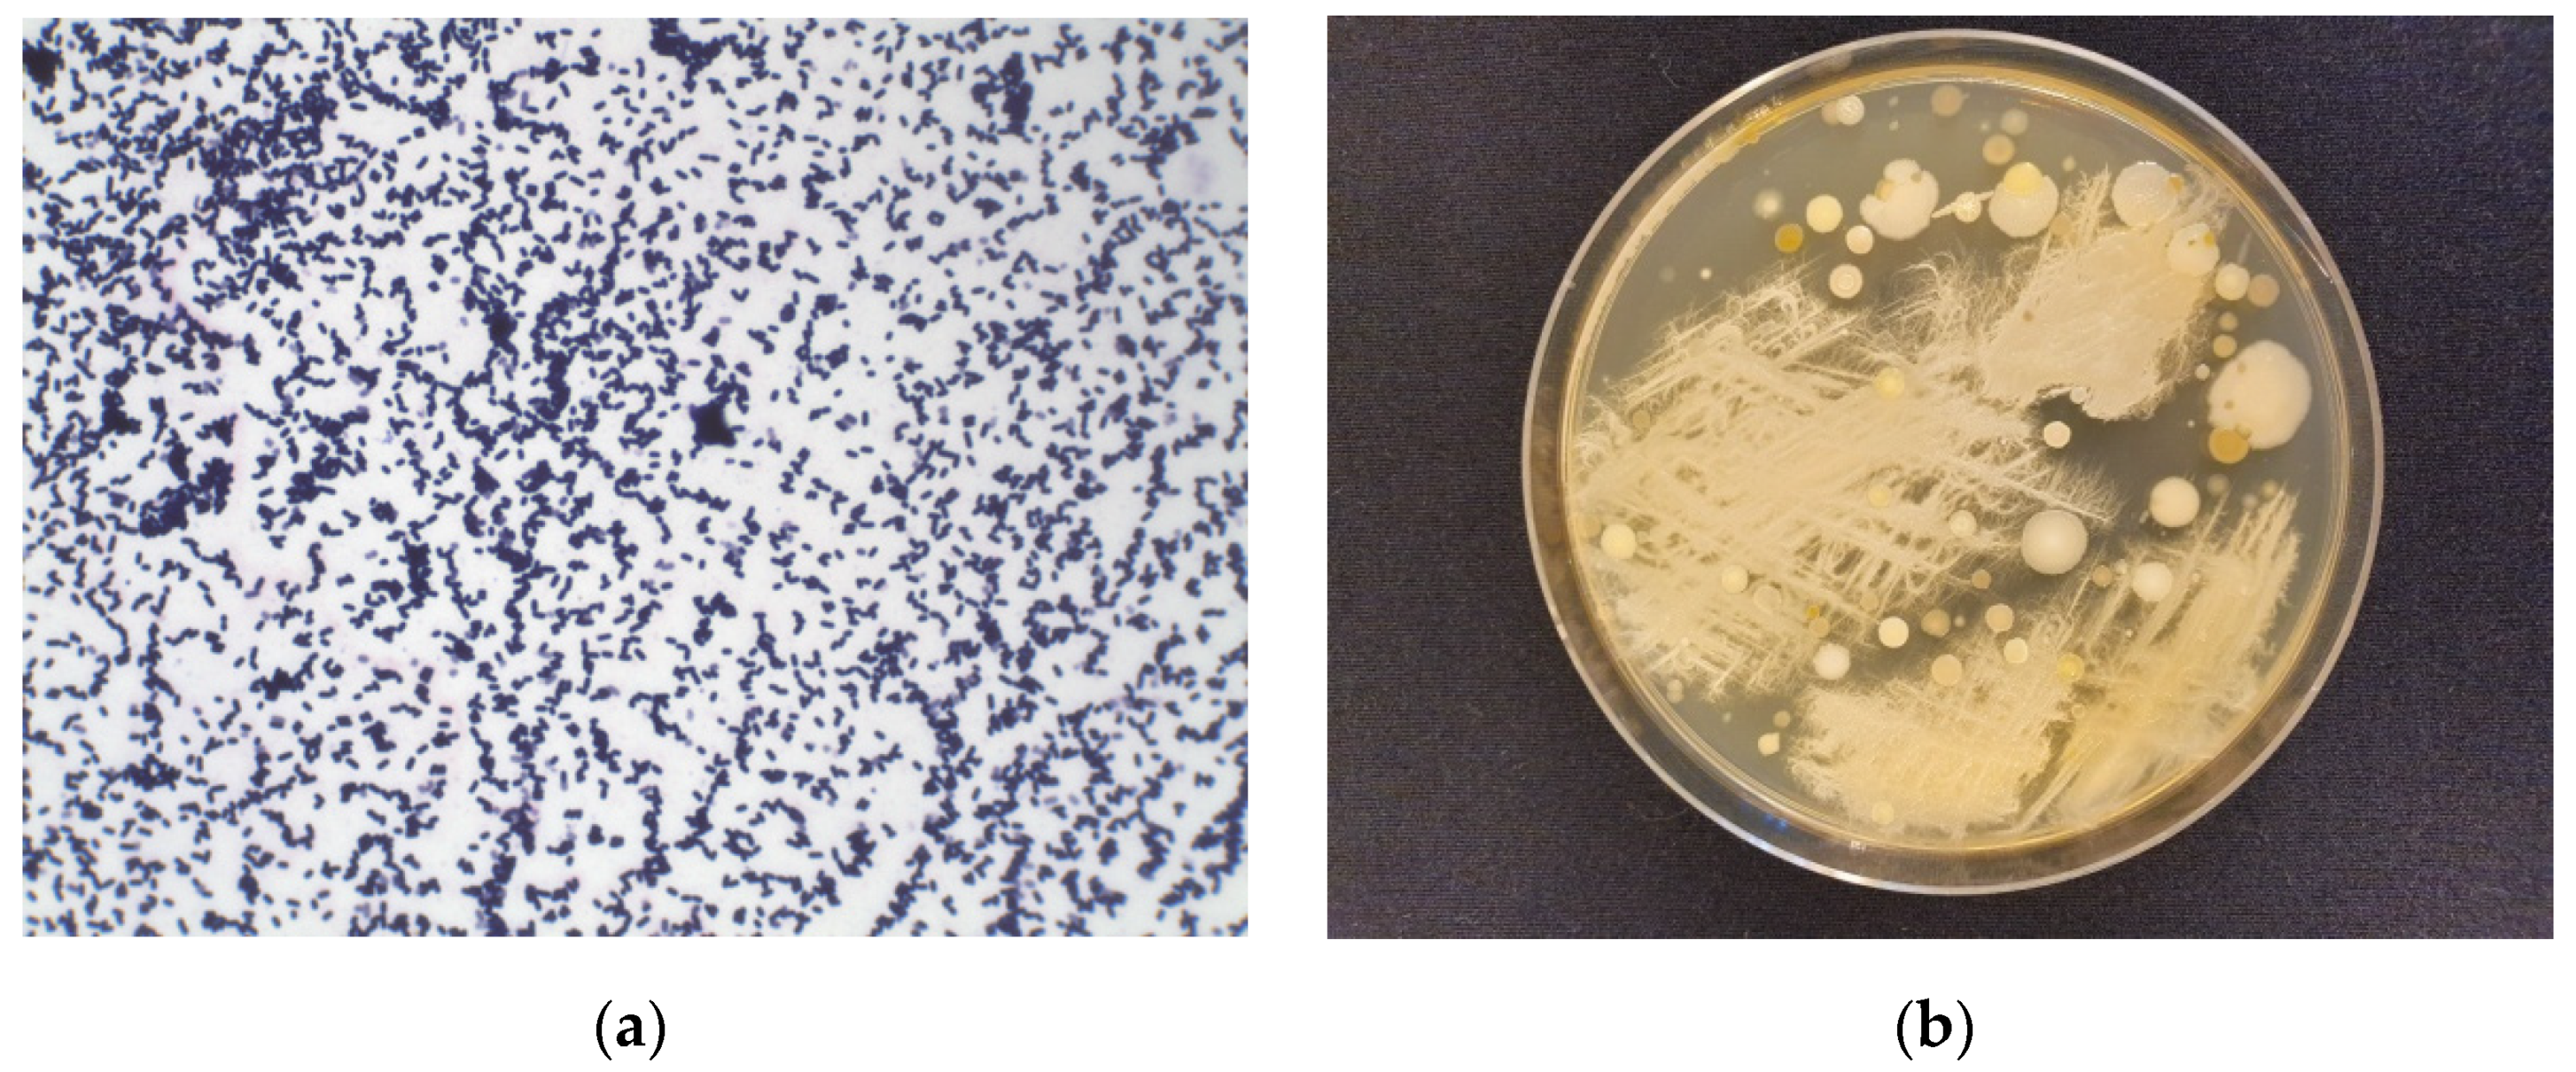

Phytochemical Profile and Anticancer Potential of Endophytic Microorganisms from Liverwort Species, Marchantia polymorpha L.
Abstract
:1. Introduction
2. Results
2.1. GC-MS Analysis of the Volatiles Present in Thalli of Marchantia polymorpha
2.2. GC-MS Analysis of the Volatile Components Present in Endophytic Microorganisms from Thalli of M. polymorpha
2.3. Cytotoxicity of Endophyte Extracts
3. Discussion
4. Materials and Methods
4.1. Plant Material
4.2. Endophyte Cultivation
4.3. Extraction and Chromatographic Analysis
4.4. Cytotoxicity Testing
5. Conclusions
Author Contributions
Funding
Institutional Review Board Statement
Informed Consent Statement
Data Availability Statement
Acknowledgments
Conflicts of Interest
References
- Martinez-Klimova, E.; Rodríguez-Peña, K.; Sánchez, S. Endophytes as sources of antibiotics. Biochem. Pharmacol. 2017, 134, 1–17. [Google Scholar] [CrossRef] [PubMed]
- Radić, N.; Štrukelj, B. Endophytic fungi—The treasure chest of antibacterial substances. Phytomedicine 2012, 19, 1270–1284. [Google Scholar] [CrossRef] [PubMed]
- Owen, N.L.; Hundley, N. Endophytes—The chemical synthesizers inside plants. Sci. Prog. 2005, 87, 79–99. [Google Scholar] [CrossRef] [PubMed]
- Verma, V.; Sudan, P.; Kour, A. Endophytes: A novel source for bioactive molecules. Prod. Indian Natl. Sci. Acad. 2008, 86, 73–86. [Google Scholar]
- Aly, A.H.; Debbab, A.; Proksch, P. Fungal endophytes—Secret producers of bioactive plant metabolites. Pharmazie 2013, 68, 499–505. [Google Scholar] [PubMed]
- Strobel, G.; Daisy, B.; Castillo, U.; Harper, J. Natural Products from Endophytic Microorganisms. J. Nat. Prod. 2004, 67, 257–268. [Google Scholar] [CrossRef]
- Tan, R.X.; Zou, W.X. Endophytes: A Rich Source of Functional Metabolites. Nat. Prod. Rep. 2001, 18, 448–459. [Google Scholar] [CrossRef] [PubMed]
- Asakawa, Y.; Ludwiczuk, A. Chemical Constituents of Bryophytes: Structures and Biological Activity. J. Nat. Prod. 2018, 81, 641–660. [Google Scholar] [CrossRef]
- He, X.; Sun, Y.; Zhu, R.L. The Oil Bodies of Liverworts: Unique and Important Organelles in Land Plants. CRC. Crit. Rev. Plant. Sci. 2013, 32, 293–302. [Google Scholar] [CrossRef]
- Asakawa, Y.; Ludwiczuk, A.; Nagashima, F. Phytochemical and biological studies of bryophytes. Phytochemistry 2013, 91, 52–80. [Google Scholar] [CrossRef] [PubMed]
- Asakawa, Y.; Ludwiczuk, A.; Nagashima, F. Chemical constituents of bryophytes: Bio- and chemical diversity, biological activity and chemosystematics. In Progress in the Chemistry of Organic Natural Product; Kinghorn, A.D., Falk, H., Kobayashi, J., Eds.; Springer: Vienna, Austria, 2013; Volume 95, pp. 1–796. [Google Scholar]
- Nelson, J.; Shaw, A.J. Exploring the natural microbiome of the model liverwort: Fungal endophyte diversity in Marchantia polymorpha L. Symbiosis 2019, 78, 45–59. [Google Scholar] [CrossRef]
- Alcaraz, L.D.; Peimbert, M.; Barajas, H.R.; Dorantes-Acosta, A.E.; Bowman, J.L.; Arteaga-Vázquez, M.A. Marchantia liverworts as a proxy to plants’ basal microbiomes. Sci. Rep. 2018, 8, 12712. [Google Scholar] [CrossRef] [PubMed]
- Huang, W.J.; Wu, C.L.; Lin, C.W.; Chi, L.L.; Chen, P.Y.; Chiu, C.J.; Huang, C.Y.; Chen, C.N. Marchantin A, a cyclic bis(bibenzyl ether), isolated from the liverwort Marchantia emarginata subsp. tosana induces apoptosis in human MCF-7 breast cancer cells. Cancer Lett. 2010, 291, 108–119. [Google Scholar] [CrossRef] [PubMed]
- Gaweł-Bęben, K.; Osika, P.; Asakawa, Y.; Antosiewicz, B.; Głowniak, K.; Ludwiczuk, A. Evaluation of anti-melanoma and tyrosinase inhibitory properties of marchantin A, a natural macrocyclic bisbibenzyl isolated from Marchantia species. Phytochem. Lett. 2019, 31, 192–195. [Google Scholar] [CrossRef]
- Jensen, S.; Omarsdottir, S.; Bwalya, A.G.; Nielsen, M.A.; Tasdemir, D.; Olafsdottir, E.S. Marchantin A, a macrocyclic bisbibenzyl ether, isolated from the liverwort Marchantia polymorpha, inhibits protozoal growth in vitro. Phytomedicine 2012, 19, 1191–1195. [Google Scholar] [CrossRef]
- Tanaka, M.; Esaki, T.; Kenmoku, H.; Koeduka, T.; Kiyoyama, Y.; Masujima, T.; Asakawa, Y.; Matsui, K. Direct evidence of specific localization of sesquiterpenes and marchantin A in oil body cells of Marchantia polymorpha L. Phytochemistry 2016, 130, 77–84. [Google Scholar] [CrossRef]
- Ludwiczuk, A.; Asakawa, Y. Bryophytes as a source of bioactive volatile terpenoids—A review. Food Chem. Toxicol. 2019, 132, 110649. [Google Scholar] [CrossRef]
- Asakawa, Y.; Ludwiczuk, A.; Novakovic, M.; Bukvicki, D.; Anchang, K.Y. Bis-bibenzyls, Bibenzyls, and Terpenoids in 33 Genera of the Marchantiophyta (Liverworts): Structures, Synthesis, and Bioactivity. J. Nat. Prod. 2021, 11, 1317–1318. [Google Scholar] [CrossRef]
- Linde, J.; Combrinck, S.; Van Vuuren, S.; Van Rooy, J.; Ludwiczuk, A.; Mokgalaka, N. Volatile constituents and antimicrobial activities of nine South African liverwort species. Phytochem. Lett. 2016, 16, 61–69. [Google Scholar] [CrossRef]
- Li, X.B.; Dobretsov, S.; Xu, Y.; Xiao, X.; Hung, O.; Qian, P.Y. Antifouling diketopiperazines produced by a deep-sea bacterium, Streptomyces fungicidicus. Biofouling 2006, 22, 187–194. [Google Scholar] [CrossRef]
- Bojarska, J.; Mieczkowski, A.; Ziora, Z.; Skwarczynski, M.; Toth, I.; Shalash, A.O.; Parang, K.; El-Mowafi, S.A.; Mohammed, E.H.M.; Elnagdy, S.; et al. Cyclic dipeptides: The biological and structural landscape with special focus on the anti-cancer proline-based scaffold. Biomolecules 2021, 11, 1515. [Google Scholar] [CrossRef] [PubMed]
- Li, X.B.; Li, Y.L.; Zhou, J.C.; Yuan, H.Q.; Wang, X.N.; Lou, H.X. A new diketopiperazine heterodimer from an endophytic fungus Aspergillus niger. J. Asian Nat. Prod. Res. 2015, 17, 182–187. [Google Scholar] [CrossRef] [PubMed]
- Zin, N.M.; Baba, M.S.; Zainal-Abidin, A.H.; Latip, J.; Mazlan, N.W.; Edrada-Ebel, R.A. Gancidin W, a potential low-toxicity antimalarial agent isolated from an endophytic Streptomyces SUK10. Drug Des. Dev. Ther. 2017, 11, 351–363. [Google Scholar] [CrossRef] [PubMed] [Green Version]
- Ravi, L.; Ragunathan, A.; Krishnan, K. Antidiabetic and Antioxidant Potential of Gancidin W from Streptomyces paradoxus VITALK03. Open Bioact. Compd. J. 2017, 5, 31–42. [Google Scholar] [CrossRef] [Green Version]
- Guo, L.; Wu, J.Z.; Han, T.; Cao, T.; Rahman, K.; Qin, L.P. Chemical composition, antifungal and antitumor properties of ether extracts of Scapania verrucosa Heeg. and its endophytic fungus Chaetomium fusiforme. Molecules 2008, 13, 2114–2125. [Google Scholar] [CrossRef] [Green Version]
- Peng, W.; Guo, L.; Jiang, Y.P.; Han, T.; Qin, L.P. Chemical constituents of the endophytic fungus Xylaria sp. isolated from the liverwort Scapania verrucosa. Chem. Nat. Compd. 2013, 49, 730–731. [Google Scholar] [CrossRef]
- Song, X.Q.; Zhang, X.; Han, Q.J.; Li, X.B.; Li, G.; Li, R.J.; Jiao, Y.; Zhou, J.C.; Lou, H.X. Xanthone derivatives from Aspergillus sydowii, an endophytic fungus from the liverwort Scapania ciliata S. Lac and their immunosuppressive activities. Phytochem. Lett. 2013, 6, 318–321. [Google Scholar] [CrossRef]
- Xie, F.; Li, X.B.; Zhou, J.C.; Xu, Q.Q.; Wang, X.N.; Yuan, H.Q.; Lou, H.X. Secondary Metabolites from Aspergillus fumigatus, an Endophytic Fungus from the Liverwort Heteroscyphus tener (Steph.) Schiffn. Chem. Biodivers. 2015, 12, 1313–1321. [Google Scholar] [CrossRef]
- Li, X.B.; Xie, F.; Liu, S.S.; Li, Y.; Zhou, J.C.; Liu, Y.Q.; Yuan, H.Q.; Lou, H.X. Naphtho-γ-pyrones from endophyte Aspergillus niger occurring in the liverwort Heteroscyphus tener (Steph.) Schiffn. Chem. Biodivers. 2013, 10, 1193–1201. [Google Scholar] [CrossRef]
- Ali, T.; Inagaki, M.; Chai, H.B.; Wieboldt, T.; Rapplye, C.; Harinantenaina Rakotondraibe, L. Halogenated Compounds from Directed Fermentation of Penicillium concentricum, an Endophytic Fungus of the Liverwort Trichocolea tomentella. J. Nat. Prod. 2017, 80, 1397–1403. [Google Scholar] [CrossRef]
- Anaya-Eugenio, G.D.; Ali, T.; Rakotondraibe, L.H.; Carcache De Blanco, E. Cytotoxic constituents from Penicillium concentricum, an endophytic fungus from Trichocolea tomentella. Anticancer. Drugs 2019, 30, 323–329. [Google Scholar] [CrossRef] [PubMed]
- Jiao, Y.; Zhang, X.; Wang, L.; Li, G.; Zhou, J.C.; Lou, H.X. Metabolites from Penicillium sp.; An endophytic fungus from the liverwort Riccardia multifida (L.) S. Gray. Phytochem. Lett. 2013, 6, 14–17. [Google Scholar] [CrossRef]

| Compound | RI | MaPo |
|---|---|---|
| 7-epi-α-Cedrene | 1405 | tr |
| Italicene | 1406 | tr |
| α-Microbiotene | 1421 | tr |
| β-Funebrene | 1427 | tr |
| Thujopsene | 1438 | 1.3 |
| Isobazanene | 1440 | 0.7 |
| (E)-β-Farnesene | 1452 | 0.8 |
| Myltayl-8(12)-ene | 1457 | 0.6 |
| 10-epi-Muurola-4,11-diene | 1466 | tr |
| β-Acoradiene | 1469 | 0.7 |
| β-Microbiotene | 1472 | 0.8 |
| Selina-4,11-diene | 1475 | 0.9 |
| α-Neocallitropsene | 1478 | 3.2 |
| β-Chamigrene | 1485 | 4.9 |
| α-Selinene | 1499 | tr |
| α-Cuprenene | 1504 | tr |
| β-Alaskene | 1506 | 1.0 |
| Cuparene | 1512 | 11.7 |
| β-Curcumene | 1537 | 1.1 |
| δ-Cuprenene | 1551 | 2.7 |
| Cyclopropanecuparenol | 1593 | 10.8 |
| epi-Cyclopropanecuparenol | 1596 | 22.3 |
| 222[M]+, 111(100), 94(74), 69(73), 55(49), 43(51) | 1637 | 2.4 |
| 220[M]+, 94(100), 111(84), 69(89), 55(41), 43(21) | 1647 | 1.9 |
| 222[M]+,109(100), 95(96), 84(94), 55(60), 43(58) | 1668 | 7.0 |
| Acorenone B | 1695 | 2.6 |
| 222[M]+, 111(100), 93(39), 83(32), 55(25), 41(15) | 1702 | 1.6 |
| 218[M]+, 147(100), 119(68), 91(43), 55(33), 41(38) | 1708 | 1.3 |
| β-Herbertenol | 1780 | tr |
| Cuparophenol | 1790 | 0.8 |
| ent-9-oxo-α-Chamigrene | 1806 | 0.7 |
| Neophytadiene (Isomer 2) | 1835 | 1.0 |
| 256[M]+, 73(100),213(31), 129(67), 57(92), 43(73) | 1966 | 2.1 |
| Phytol | 2109 | 1.5 |
| 280[M]+, 79(100), 95(56), 67(66), 55(88), 41(58) | 2141 | 0.9 |
| Compound | RI | Hexane Extract | Ethyl Acetate Extract |
|---|---|---|---|
| Anthranilic acid | 1415 | − | + |
| N-Phenetylacetamide | 1508 | − | + |
| 2,2-Dimethyl-N-phenethylpropionamide | 1719 | + | + |
| Pyrrolidino [1,2-a]piperazine-3,6-dione | 1764 | − | + |
| Cyclo(leucylprolyl) = Gancidin W | 1929 | − | + |
| N-(Phenethyl)phenylacetamid | 2128 | + | − |
| Cyclo(phenylalanylprolyl) | 2377 | − | + |
| Pentadecanoic acid | 1828 | + | + |
| Hexadecanoic acid | 1963 | + | + |
| Methyl pentadecanoate | 1783 | + | + |
| Methyl hexadecanoate | 1884 | − | + |
| Methyl 9-hexadecenoate | 1903 | + | + |
| Pentadecane | 1497 | − | + |
Publisher’s Note: MDPI stays neutral with regard to jurisdictional claims in published maps and institutional affiliations. |
© 2021 by the authors. Licensee MDPI, Basel, Switzerland. This article is an open access article distributed under the terms and conditions of the Creative Commons Attribution (CC BY) license (https://creativecommons.org/licenses/by/4.0/).
Share and Cite
Stelmasiewicz, M.; Świątek, Ł.; Ludwiczuk, A. Phytochemical Profile and Anticancer Potential of Endophytic Microorganisms from Liverwort Species, Marchantia polymorpha L. Molecules 2022, 27, 153. https://doi.org/10.3390/molecules27010153
Stelmasiewicz M, Świątek Ł, Ludwiczuk A. Phytochemical Profile and Anticancer Potential of Endophytic Microorganisms from Liverwort Species, Marchantia polymorpha L. Molecules. 2022; 27(1):153. https://doi.org/10.3390/molecules27010153
Chicago/Turabian StyleStelmasiewicz, Mateusz, Łukasz Świątek, and Agnieszka Ludwiczuk. 2022. "Phytochemical Profile and Anticancer Potential of Endophytic Microorganisms from Liverwort Species, Marchantia polymorpha L." Molecules 27, no. 1: 153. https://doi.org/10.3390/molecules27010153
APA StyleStelmasiewicz, M., Świątek, Ł., & Ludwiczuk, A. (2022). Phytochemical Profile and Anticancer Potential of Endophytic Microorganisms from Liverwort Species, Marchantia polymorpha L. Molecules, 27(1), 153. https://doi.org/10.3390/molecules27010153

